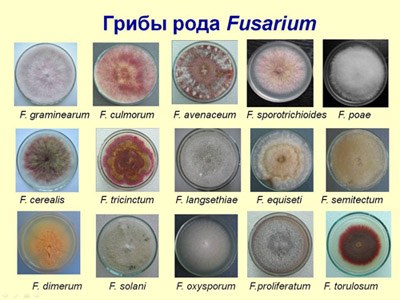

Другие названия и синонимы
Alimentary-toxic aleikia, Алиментарно-геморрагическая ангина, Острый алиментарный микотоксикоз, Септическая ангина.
МКБ-10 коды
|
|
Описание
Токсическая пищевая алеуксия. Это серьезное пищевое отравление, вызванное микотоксинами грибов рода Fusarium. Специфическим действием токсина является повреждение лимфатической ткани и костного мозга. Основными симптомами заболевания являются некротический тонзиллит и геморрагический синдром. Диагноз заключается в обнаружении возбудителя при бактериологическом исследовании крови и тканей пациента, особое внимание уделяется точному сбору анамнеза, наличию характерных изменений миндалин и лейкопении в общем клиническом анализе крови. Лечение состоит из детоксикации, системной и местной антибактериальной терапии и может включать переливание компонентов крови.

Дополнительные факты
Токсическая алейгия, также известная как септический, геморрагический тонзиллит и острый микотоксикоз, является тяжелым отравлением, вызванным грибковым токсином фузариума. Путь заражения - еда, которая в основном связана с потреблением пищи из зимующих злаков с грибковыми спорами. Патология была впервые описана в 1932 году во время эпидемии в Казахстане. найдены по всему миру. Было установлено, что жители сельскохозяйственных районов наиболее подвержены заражению. Как правило, увеличение количества случаев может наблюдаться в период с апреля по июнь. Больной человек не заразен для других.
Причины
Возбудителями заболевания являются грибы рода Fusarium, которые продуцируют токсический яд, который вызывает локальные проявления в виде некроза и обладает тропизмом к кроветворной и лимфоидной тканям. Источником инфекции являются злаки, которые служили питательной средой для размножения и накопления домашней птицы во время зимовки. К таким сельскохозяйственным растениям относятся просо, гречка, пшеница, рожь, овес и ячмень. Благоприятными условиями для роста гриба являются высокая влажность, наличие кислорода и тепла. В холодное время года грибы превращаются в споры и переживают зиму, а после начала весны они снова начинают производить заострение.
Теплая зима и ранняя весна, а также высокая влажность и другие нарушения правил хранения зерна считаются факторами риска возникновения вспышек. Токсин не разрушается при термообработке, ферментации, способен сохранять свои свойства до пяти лет, в частности при температуре хранения от + 1 ° С до + 5 ° С. Рассматриваются пациенты с иммуносупрессией (ВИЧ-инфекция, длительная терапия кортикостероидами, иммунодепрессантами), люди после спленэктомии, дети, работники фермы, работники сферы питания и общественного питания. группы риска заболевания.
Теплая зима и ранняя весна, а также высокая влажность и другие нарушения правил хранения зерна считаются факторами риска возникновения вспышек. Токсин не разрушается при термообработке, ферментации, способен сохранять свои свойства до пяти лет, в частности при температуре хранения от + 1 ° С до + 5 ° С. Рассматриваются пациенты с иммуносупрессией (ВИЧ-инфекция, длительная терапия кортикостероидами, иммунодепрессантами), люди после спленэктомии, дети, работники фермы, работники сферы питания и общественного питания. группы риска заболевания.

Патогенез
После проглатывания в слизистых оболочках происходит локальная реакция, связанная с изменениями в некротической ткани вследствие обширного воспаления. Через поверхность раны токсин интенсивно абсорбируется в крови, распространяется по всему телу, демонстрируя тропизм к миелоидному (красная инерция) и затем к лимфоидной ткани. Под влиянием острия происходит торможение кроветворения, воспалительные изменения в тимусе, селезенке, лимфатических узлах, бляшках Пейера и аппендикса. Постепенно происходит уменьшение количества эритроцитов, моноцитов, гранулоцитов, тромбоцитов, предшественников Т-лимфоцитов, В-лимфоцитов и NK-клеток, помимо макрофагов и дендритных клеток. Геморрагические изменения возникают в паренхиматозных органах, развивается кожное и септическое состояние. Иммунитет после болезни постоянен, но его продолжительность не изучена.
Классификация
В клинике пищевого микотоксикоза выделяют два варианта потока, которые напрямую зависят от количества потребляемых зерновых, токсичности штамма, концентрации токсина в пищевом продукте и иммунной компетентности организма пациента:
Характеризуется быстрым нарастанием клинических проявлений и смертностью в течение первого дня заболевания из-за ИБС или развитого сепсиса.
Он длится около 3-4 недель, характеризуется постепенным увеличением тяжести заболевания и тяжелой постановкой. Включает токсическую, лейкопеническую и ангино-геморрагическую стадии.
Характеризуется быстрым нарастанием клинических проявлений и смертностью в течение первого дня заболевания из-за ИБС или развитого сепсиса.
Он длится около 3-4 недель, характеризуется постепенным увеличением тяжести заболевания и тяжелой постановкой. Включает токсическую, лейкопеническую и ангино-геморрагическую стадии.
Клиническая картина
Инкубационный период составляет от 2 до 6 недель. При употреблении большого количества зараженных зерновых продуктов (более 500 г) симптомы появляются в течение нескольких дней. Первыми признаками отравления являются тошнота, рвота, жидкий стул, слабость, снижение работоспособности и усталость. Описанные проявления длятся около 3 дней, после чего наступает период лейкопении. Клинически это состояние проявляется в виде увеличения слабости, недомогания, сонливости (эта стадия обычно длится 2-3, реже 6-8 недель).
В дальнейшем, с обострением токсических эффектов, возникает ангино-геморрагическая стадия. Больные жалуются на повышение температуры тела (более 39 ° С), озноб, наблюдают возникновение случайных кровоизлияний (петехий) в организме, реже - экхимозы; десны и носовые кровотечения. В то же время сильная боль возникает при глотании, неприятном гнилостном дыхании, грязных отложениях пепла в миндалинах, в полости рта, гортани и глотке. По мере прогрессирования заболевания образуются мокрота и кожные абсцессы, волокна и внутренние органы.
Ассоциированные симптомы: Водянистый понос. Лейкопения. Недомогание. Озноб. Рвота. Тошнота.
В дальнейшем, с обострением токсических эффектов, возникает ангино-геморрагическая стадия. Больные жалуются на повышение температуры тела (более 39 ° С), озноб, наблюдают возникновение случайных кровоизлияний (петехий) в организме, реже - экхимозы; десны и носовые кровотечения. В то же время сильная боль возникает при глотании, неприятном гнилостном дыхании, грязных отложениях пепла в миндалинах, в полости рта, гортани и глотке. По мере прогрессирования заболевания образуются мокрота и кожные абсцессы, волокна и внутренние органы.
Ассоциированные симптомы: Водянистый понос. Лейкопения. Недомогание. Озноб. Рвота. Тошнота.
Возможные осложнения
Осложнения обычно возникают во время молниеносного течения пищевого микотоксикоза или в ангино-геморрагическом периоде типичного варианта заболевания. Наиболее распространенными являются пневмония, бронхит, абсцессы легких, флегмона мягких тканей и остеомиелит. В условиях усиления иммуносупрессии эти состояния могут привести к сепсису. В некоторых случаях наблюдается появление некротических изменений в дистальных конечностях. Дефицит системы свертывания крови, повреждение паренхиматозных органов (почек, печени, селезенки) приводят к развитию синдрома ДВС-синдрома с характерной клиникой непрерывного массивного кровотечения.
Диагностика
При подозрении на аликию токсического пищевого происхождения обязательна консультация специалиста по инфекционным заболеваниям, ЛОР-врача, пульмонолога; после появления язв на коже и внутренних органах - хирург. Для выявления возбудителя, оценки характера и серьезности изменений проводятся лабораторные и инструментальные исследования:
• Клинические и биохимические анализы крови. В общем анализе крови наблюдаются выраженная лейкопения, тромбоцитопения, анемия и ускорение СОЭ. Биохимические показатели отражают повышение активности АСТ, АЛТ, креатинина, мочевины.
• Идентификация инфекционных агентов. Выделение гриба из тканей и крови человека - трудоемкий и дорогой процесс. вacanalysis выполнен, посеивая материал на питательных веществах. Обнаружение токсина в пшенице осуществляется с использованием биологического образца (кормление лабораторных голубей подозрительной пшеницей, кожный тест на кроликах), хроматографии пшеницы.
• Эндоскопия ЛОР-органов. При осмотре глотки - фарингоскопии - обнаруживаются признаки катарального, некротического или гангренозного тонзиллита. Типичные отложения грязно-серого или коричневого цвета и проходят от миндалин к слизистой оболочке гортани, горла и полости рта. Кровотечение из слизистой оболочки носа и горла, образование некроза.
Если появляются признаки пневмонии, делают рентген грудной клетки. Ультразвуковое исследование органов брюшной полости, таза, забрюшинного пространства и лимфатических узлов используется для дифференциальной диагностики. Дифференциальная диагностика проводится при дифтерии, сепсисе, системных микозах, агранулоцитозе, тонановом синдроме Симановского-Плаута-Винсента, отравлениях тяжелыми металлами и радиоактивными веществами.
• Клинические и биохимические анализы крови. В общем анализе крови наблюдаются выраженная лейкопения, тромбоцитопения, анемия и ускорение СОЭ. Биохимические показатели отражают повышение активности АСТ, АЛТ, креатинина, мочевины.
• Идентификация инфекционных агентов. Выделение гриба из тканей и крови человека - трудоемкий и дорогой процесс. вacanalysis выполнен, посеивая материал на питательных веществах. Обнаружение токсина в пшенице осуществляется с использованием биологического образца (кормление лабораторных голубей подозрительной пшеницей, кожный тест на кроликах), хроматографии пшеницы.
• Эндоскопия ЛОР-органов. При осмотре глотки - фарингоскопии - обнаруживаются признаки катарального, некротического или гангренозного тонзиллита. Типичные отложения грязно-серого или коричневого цвета и проходят от миндалин к слизистой оболочке гортани, горла и полости рта. Кровотечение из слизистой оболочки носа и горла, образование некроза.
Если появляются признаки пневмонии, делают рентген грудной клетки. Ультразвуковое исследование органов брюшной полости, таза, забрюшинного пространства и лимфатических узлов используется для дифференциальной диагностики. Дифференциальная диагностика проводится при дифтерии, сепсисе, системных микозах, агранулоцитозе, тонановом синдроме Симановского-Плаута-Винсента, отравлениях тяжелыми металлами и радиоактивными веществами.
|
|
Лечение
Терапевтические меры начинаются с удаления отравленных продуктов с пищи, промывания желудка и сифонной клизмы (или с использованием слабительного). Рекомендуется исключить из рациона алкоголь, специи, жирную пищу, жареную пищу, крупы, придерживаться частого дробного питания, подавать пищу при комнатной температуре (чтобы избежать дополнительной травмы слизистых оболочек). Необходимо следить за режимом потребления, при этом предпочтительнее употреблять воду или некислые соки. После каждого приема пищи рекомендуется полоскать рот антисептическими растворами (хлоргексидин, фурацилина, календулы, шалфея, ромашки).
Лечение токсической алейкии у больных обычно проводится стационарно, включает детоксикационную терапию (растворы солей глюкозы) и применение антибиотиков широкого спектра действия (пенициллины, цефалоспорины). При длительном течении патологии может возникнуть необходимость восполнить потерю компонентов крови: переливается эритроцит, масса тромбоцитов, концентрат лейкоцитов. Имеются данные о положительном влиянии колониестимулирующего фактора на течение, тяжесть и исход заболевания. Во время лечения рекомендуется уменьшить дозу иммунодепрессантов или отменить их, если это возможно. Когда появляются локализованные или диффузные гнойные процессы, они открываются и дренируются, и используются местные антибактериальные средства (мази, суспензии).
Лечение токсической алейкии у больных обычно проводится стационарно, включает детоксикационную терапию (растворы солей глюкозы) и применение антибиотиков широкого спектра действия (пенициллины, цефалоспорины). При длительном течении патологии может возникнуть необходимость восполнить потерю компонентов крови: переливается эритроцит, масса тромбоцитов, концентрат лейкоцитов. Имеются данные о положительном влиянии колониестимулирующего фактора на течение, тяжесть и исход заболевания. Во время лечения рекомендуется уменьшить дозу иммунодепрессантов или отменить их, если это возможно. Когда появляются локализованные или диффузные гнойные процессы, они открываются и дренируются, и используются местные антибактериальные средства (мази, суспензии).
Прогноз
При неосложненном течении болезнь длится примерно 3-4 недели. При своевременном обращении за медицинской помощью, отказе от употребления инфицированных продуктов, проявления микотоксикоза становятся склонными к само исчезновению. С появлением геморрагического синдрома и некротических изменений в миндалинах доля смертей составляет от 50 до 80%. Однако опасные для жизни условия требуют от двух до трех месяцев постоянного потребления инфицированного зернового продукта даже в условиях явного недомогания. Своевременная госпитализация и тщательное эпидемиологическое расследование снижают риск смерти и осложнений.
Профилактика
Специфическая профилактика (вакцины) на данном этапе развития медицины не разработана. Для предотвращения заражения органами санитарного надзора проводятся периодические проверки зерна, а также разъяснительная работа с населением. Продажа и покупка перезимованного зерна для пищевых нужд людей и животных запрещена (разрешена доставка на спиртзаводы). На территории, где были зафиксированы спорадические случаи токсической алейкии, следует утилизировать зерновые продукты и их сырье; население должно быть проверено на лейкопению.
Список литературы
1. Научное обоснование административных мероприятий по ликвидации «Септической ангины» в Оренбуржье/ Ляшенко И.Э. Вестник Оренбургского государственного университета. 2017.
2. Алиментарно-токсическая алейкия (септическая ангина). Автореферат диссертации/ Колчина А.И. 1951.
3. К истории изучения «Септической ангины»: вклад ученых Воронежского медицинского института/ Маркова С.В., Золоедов В.И. Гематология и трансфузиология. 2015.
2. Алиментарно-токсическая алейкия (септическая ангина). Автореферат диссертации/ Колчина А.И. 1951.
3. К истории изучения «Септической ангины»: вклад ученых Воронежского медицинского института/ Маркова С.В., Золоедов В.И. Гематология и трансфузиология. 2015.